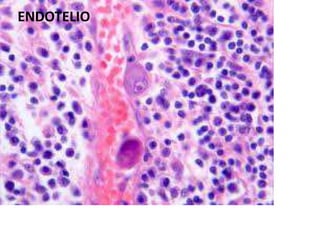
ENDOTELIO
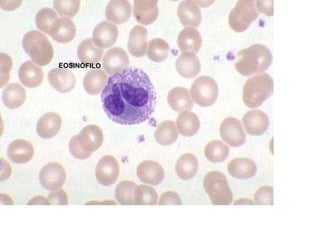
EOSINÓFILO

Incrustar presentación
Descargado 29 veces


































La histología es el estudio de los tejidos. Un tejido está compuesto por células relacionadas que realizan funciones comunes. Existen diferentes tipos de tejidos como el epitelio, el tejido conectivo y el tejido muscular. La histología estudia la estructura y función de los tejidos a nivel microscópico.